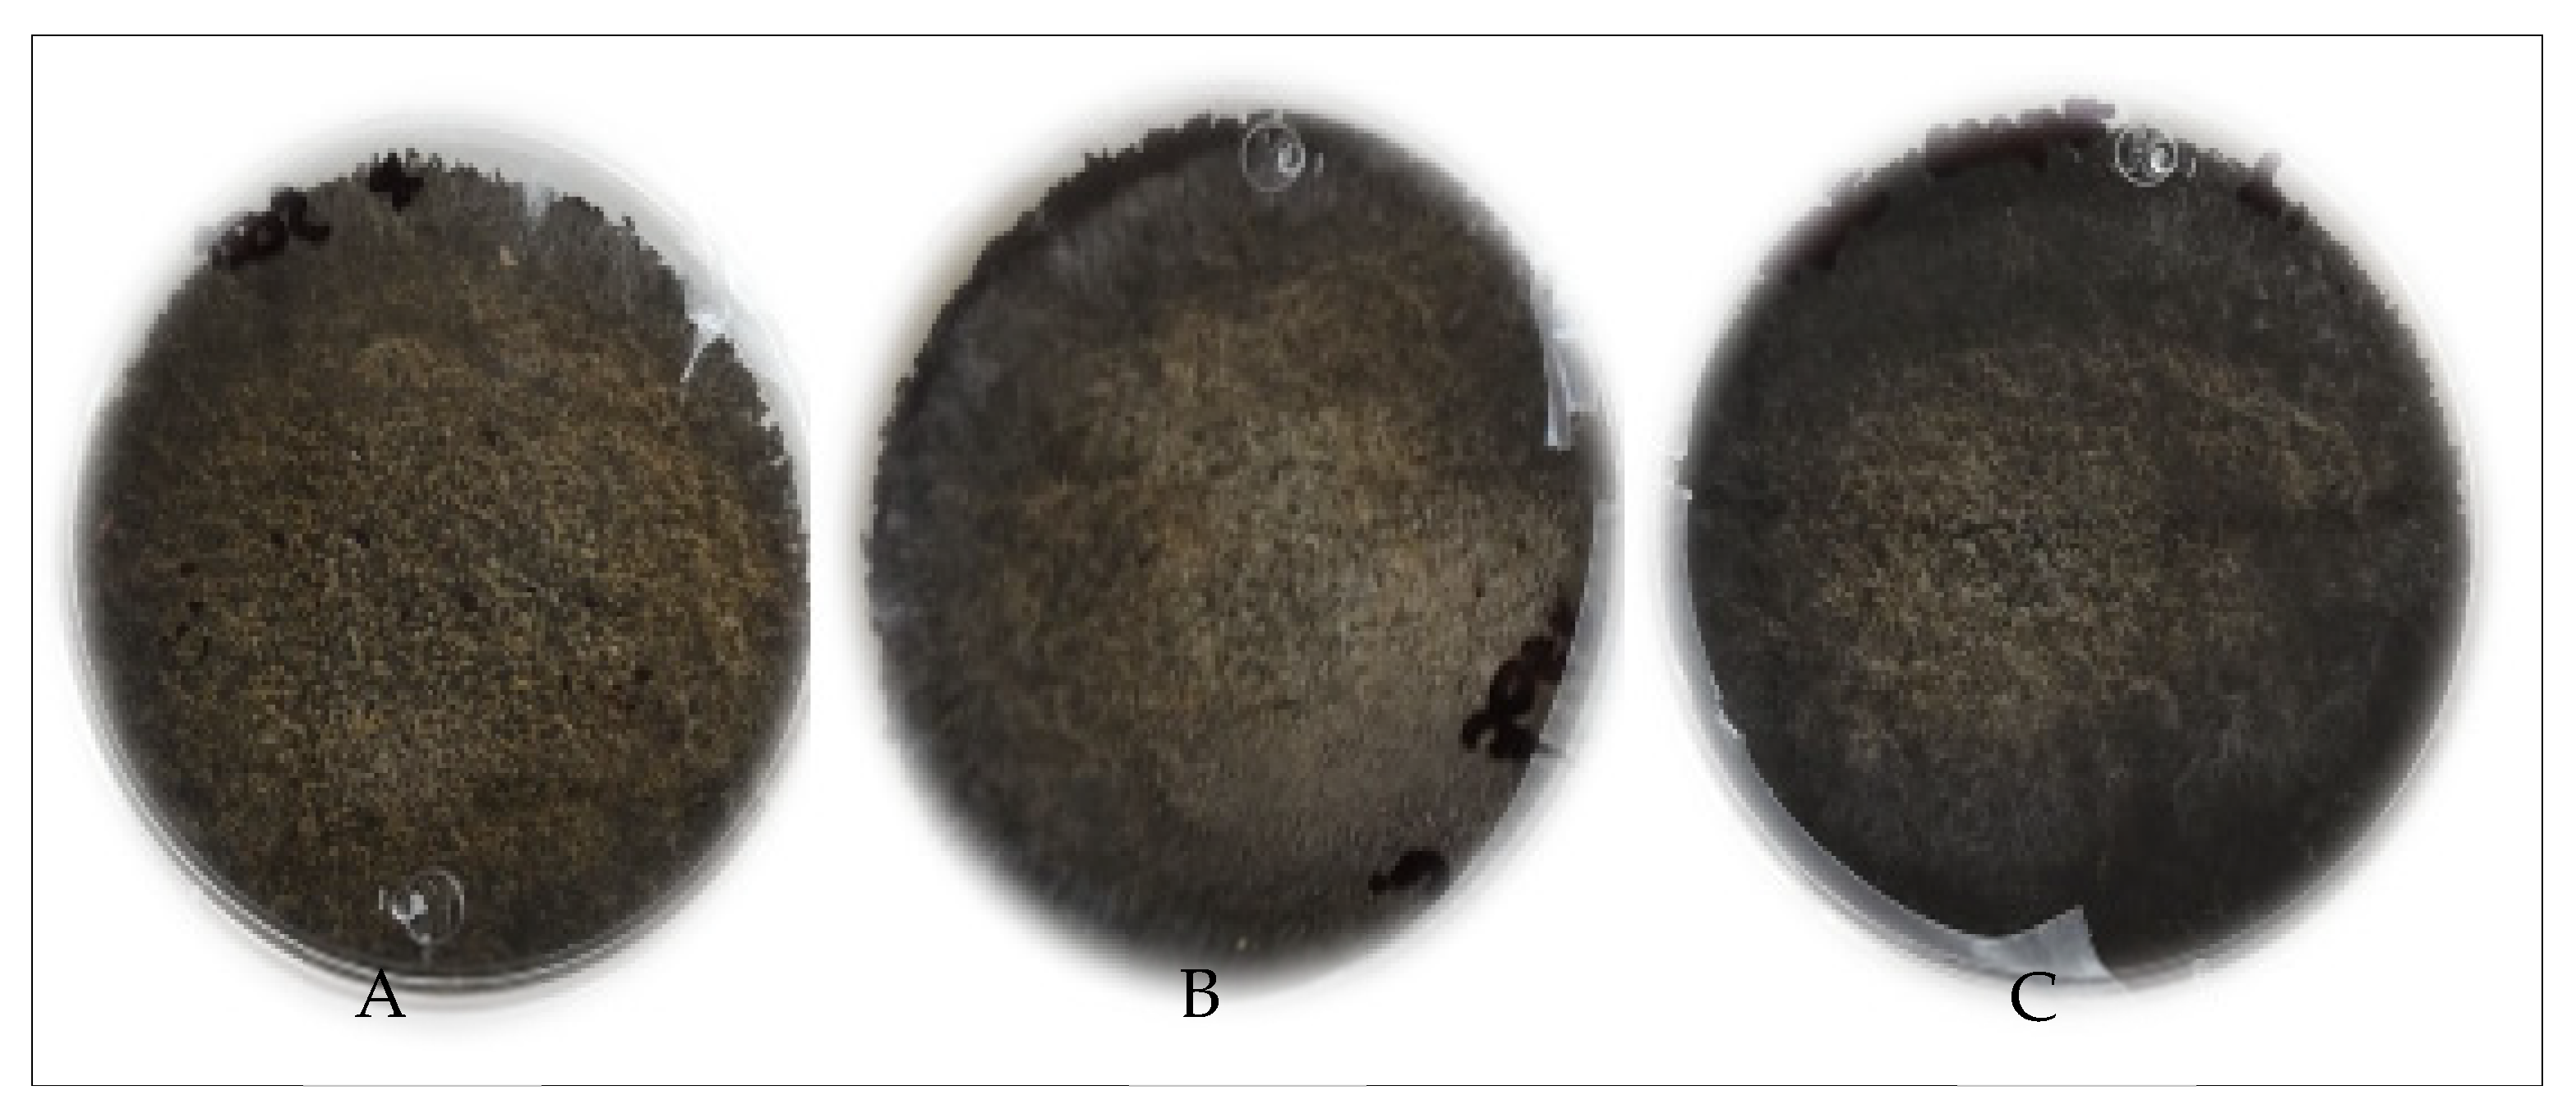
Molecules 27 03887 g004 Molecules 27 03887 g004

Fungal Proteins from Sargassum spp. Using Solid-State Fermentation as a Green Bioprocess Strategy
Abstract
1. Introduction
2. Results
2.1. Physicochemical and Bromatological Characterization of the Biomass of Sargassum spp.
2.2. Characterization of the Elemental Composition of Sargassum spp.
2.3. Hydrothermal Pretreatment of Sargassum spp.
2.4. Fungal Radial Growth on Pretreated Sargassum spp.
2.5. Solid-State Fermentation on Sargassum spp. Hydrothermally Pretreated at 170 °C
2.6. Production of Fungal Proteins from Aspergillus oryzae on Sargassum spp. after Hydrothermal Pretreatment at 170 °C
2.7. Production of Fungal Proteins from Aspergillus oryzae on Sargassum spp. after Hydrothermal Pretreatment at 170 °C Using a Packed-Bed Bioreactor
2.8. Scanning Electron Microscopy
3. Discussion
4. Materials and Methods
4.1. Sargassum Biomass Collection and Preparation
4.2. Physicochemical Characterization of Sargassum biomass
4.2.1. Elemental Composition Characterization
4.2.2. pH
4.3. Hydrothermal Pretreatment of Sargassum spp. Biomass
4.4. Preparation of the Inoculum and Radial Growth of Aspergillus fungi
4.5. Solid-State Fermentation on Pretreated Sargassum spp. Biomass
4.6. Solid-State Fermentation (Packed-Bed Bioreactor) in Pretreated Sargassum spp. Biomass
4.7. Scanning Electron Microscopy in the Fermented Biomass of Sargassum spp.
4.8. Statistical Analyses
5. Conclusions
Author Contributions
Funding
Institutional Review Board Statement
Informed Consent Statement
Data Availability Statement
Acknowledgments
Conflicts of Interest
Sample Availability
References
- Wang, M.; Hu, C. Remote Sensing of Environment Mapping and quantifying Sargassum distribution and coverage in the Central West Atlantic using MODIS observations. Remote Sens. Environ. 2016, 183, 350–367. [Google Scholar] [CrossRef]
- Smetacek, V.; Zingone, A. Green and golden seaweed tides on the rise. Nature 2013, 504, 84–88. [Google Scholar] [CrossRef] [PubMed]
- Strokal, M.; Kroeze, C. Nitrogen and phosphorus inputs to the Black Sea in 1970—2050. Reg. Environ. Chang. 2013, 13, 179–192. [Google Scholar] [CrossRef]
- Resiere, D.; Valentino, R.; Nevière, R.; Banydeen, R.; Gueye, P.; Florentin, J.; Cabié, A.; Lebrun, T.; Mégarbane, B.; Guerrier, G.; et al. Sargassum seaweed on Caribbean islands: An international public health concern. Lancet 2018, 392, 2691. [Google Scholar] [CrossRef]
- Hu, C.; Murch, B.; Barnes, B.B.; Wang, M.; Maréchal, J.P.; Franks, J.; Johnson, D.; Lapointe, B.; Goodwin, D.; Schell, J.; et al. Sargassum watch warns of incoming seaweed. Eos 2016, 97, 10–15. [Google Scholar] [CrossRef]
- Milledge, J.J.; Harvey, P.J. Golden tides: Problem or golden ppportunity? The valorisation of sargassum from beach inundations. J. Mar. Sci. Eng. 2016, 4, 60. [Google Scholar] [CrossRef]
- Sarmiento-Padilla, A.L.; Moreira, S.; Rocha, H.A.O.; Araújo, R.G.; Govea-Salas, M.; Pinales-Márquez, C.D.; Ruiz, H.A.; Rodríguez-Jasso, R.M. Circular bioeconomy in the production of fucoxanthin from aquatic biomass: Extraction and bioactivities. J. Chem. Technol. Biotechnol. 2022, 97, 1363–1378. [Google Scholar] [CrossRef]
- Kostas, E.T.; Adams, J.M.M.; Ruiz, H.A.; Durán-Jiménez, G.; Lye, G.J. Macroalgal biorefinery concepts for the circular bioeconomy: A review on biotechnological developments and future perspectives. Renew. Sustain. Energy Rev. 2021, 151, 111553. [Google Scholar] [CrossRef]
- Rodríguez-Jasso, R.M.; Mussatto, S.I.; Pastrana, L.; Aguilar, C.N.; Teixeira, J.A. Microwave-assisted extraction of sulfated polysaccharides (fucoidan) from brown seaweed. Carbohydr. Polym. 2011, 86, 1137–1144. [Google Scholar] [CrossRef]
- Aparicio, E.; Rodríguez-Jasso, R.M.; Lara, A.; Loredo-Triviño, A.; Aguilar, C.N.; Kostas, E.T.; Ruiz, H.A. Biofuels production of third generation biorefinery from macroalgal biomass in the Mexican context: An overview. In Sustainable Seaweed technologies. Cultivation, Biorefinery, and Applications; Torres, M.D., Kraan, S., Dominguez, H., Eds.; Elsevier: Amsterdam, The Netherlands, 2020; pp. 393–446. [Google Scholar]
- Lara, A.; Rodríguez-Jasso, R.M.; Loredo-Treviño, A.; Aguilar, C.N.; Meyer, A.S.; Ruiz, H.A. Enzymes in the third generation biorefinery for macroalgae biomass. In Biomass, Biofuels, Biochemicals. Advance in Enzyme Catalysis and Technologies; Singh, S.P., Singhania, R.R., Li, Z., Pandey, A., Larroche, C., Eds.; Elsevier: Amsterdam, The Netherlands, 2020; pp. 363–396. [Google Scholar]
- González-Gloria, K.D.; Rodríguez-Jasso, R.M.; Shiva, E.; González, M.L.C.; Kostas, E.T.; Ruiz, H.A. Macroalgal biomass in terms of third-generation biorefinery concept: Current status and techno-economic analysis—A review. Bioresour. Technol. Rep. 2021, 16, 100863. [Google Scholar] [CrossRef]
- Farhan, M.; Yusoff, F.; Suryani, E.; Aliyu, M. Brown seaweed Sargassum polycystum as dietary supplement exhibits prebiotic potentials in Asian sea bass Lates calcarifer fingerlings. Aquac. Rep. 2020, 18, 100488. [Google Scholar]
- Aparicio, E.; Rodríguez-Jasso, R.M.; Pinales-Márquez, C.D.; Loredo-Treviño, A.; Robledo-Olivo, A.; Aguilar, C.N.; Kostas, E.T.; Ruiz, H.A. High-pressure technology for Sargassum spp biomass pretreatment and fractionation in the third generation of bioethanol production. Bioresour. Technol. 2021, 329, 124935. [Google Scholar] [CrossRef] [PubMed]
- Ruiz, H.A.; Rodriguez, R.M.; Fernandes, B.; Dvicente, A.; Teixeira, A. Hydrothermal processing, as an alternative for upgrading agriculture residues and marine biomass according to the biorefinery concept: A review. Renew. Sustain. Energy Rev. 2013, 21, 35–51. [Google Scholar] [CrossRef]
- Ruiz, H.A.; Conrad, M.; Sun, S.N.; Sanchez, A.; Rocha, G.J.; Romaní, A.; Castro, E.; Torres, A.; Rodríguez-Jasso, R.M.; Andrade, L.P.; et al. Engineering aspects of hydrothermal pretreatment: From batch to continuous operation, scale-up and pilot reactor under biorefinery concept. Bioresour. Technol. 2020, 299, 122685. [Google Scholar] [CrossRef]
- Morales-Contreras, B.E.; Flóres-Fernández, N.; Torres, D.M.; Domínguez, H.; Rodríguez-Jasso, R.M.; Ruiz, H.A. Hydrothermal systems to obtain high value-added compounds from macroalgae for bioeconomy and biorefineries. Bioresour. Technol. 2022, 343, 126017. [Google Scholar] [CrossRef]
- Rodríguez-Jasso, R.M.; Mussatto, S.I.; Sepúlveda, L.; Agrasar, A.T.; Pastrana, L.; Aguilar, C.N.; Teixeira, J.A. Fungal fucoidanase production by solid-state fermentation in a rotating drum bioreactor using algal biomass as substrate. Food Bioprod. Process. 2013, 91, 587–594. [Google Scholar] [CrossRef]
- Marrion, O.; Schwertz, A.; Fleurence, J.; Guøant, J.L.; Villaume, C. Improvement of the digestibility of the proteins of the red alga Palmaria palmata by physical processes and fermentation. Nahrung 2003, 47, 339–344. [Google Scholar] [CrossRef]
- Ruiz, H.A.; Rodríguez-Jasso, R.M.; Rodríguez, R.; Contreras-Esquivel, J.C.; Aguilar, C.N. Pectinase production from lemon peel pomace as support and carbon source in solid-state fermentation column-tray bioreactor. Biochem. Eng. J. 2012, 65, 90–95. [Google Scholar] [CrossRef]
- Londoño-Hernández, L.; Ramírez-Toro, C.; Ruiz, H.A.; Ascacio-Valdés, J.A.; Aguilar-Gonzalez, M.A.; Rodríguez-Herrera, R.; Aguilar, C.N. Rhizopus oryzae—Ancient microbial resource with importance in modern food industry. Int. J. Food Microbiol. 2017, 257, 110–127. [Google Scholar] [CrossRef]
- Ferreira, J.A.; Mahboubi, A.; Lennartsson, P.R.; Taherzadeh, M.J. Waste biorefineries using filamentous ascomycetes fungi: Present status and future prospects. Bioresour. Technol. 2016, 215, 334–345. [Google Scholar] [CrossRef]
- Souza, P.F.; Akram, F.; Mohammad, Z. Edible protein production by filamentous fungi using starch plant wastewater. Waste Biomass Valorization 2019, 10, 2487–2496. [Google Scholar] [CrossRef]
- Misurcova, L.; Machu, L.; Jana, O. Seaweed minerals as nutraceuticals. In Advances in Food and Nutrition Research; Kim, S.-K., Ed.; Elsevier: Amsterdam, The Netherlands, 2011; pp. 371–390. [Google Scholar]
- Kumari, R.; Kaur, I.; Bhatnagar, A.K. Effect of aqueous extract of Sargassum johnstonii Setchell & Gardner on growth, yield and quality of Lycopersicon esculentum Mill. J. Appl. Phycol. 2011, 23, 623–633. [Google Scholar]
- Kumari, R.; Kaur, I.; Bhatnagar, A.K. Enhancing soil health and productivity of Lycopersicon esculentum Mill. using Sargassum johnstonii Setchell & Gardner as a soil conditioner and fertilizer. J. Appl. Phycol. 2013, 25, 1225–1235. [Google Scholar]
- Ismail, G.A. Biochemical composition of some Egyptian seaweeds with potent nutritive and antioxidant properties. Food Sci. Technol. 2017, 37, 294–302. [Google Scholar] [CrossRef]
- Peñalver, R.; Lorenzo, J.M.; Ros, G.; Amarowicz, R.; Pateiro, M.; Nieto, G. Seaweeds as a functional ingredient for a healthy diet. Mar. Drugs 2020, 18, 301. [Google Scholar] [CrossRef] [PubMed]
- Seepersaud, M.A.; Ramkissoon, A.; Seecharan, S.; Powder-George, Y.L.; Mohammed, F.K. Environmental monitoring of heavy metals and polycyclic aromatic hydrocarbons (PAHs) in Sargassum filipendula and Sargassum vulgare along the eastern coastal waters of Trinidad and Tobago, West Indies. J. Appl. Phycol. 2018, 30, 2143–2154. [Google Scholar] [CrossRef]
- Jayakumar, V.; Govindaradjane, S.; Rajamohan, N.; Rajasimman, M. Biosorption potential of brown algae, Sargassum polycystum, for the removal of toxic metals, cadmium and zinc. Environ. Sci. Pollut. 2022, 29, 41909–41922. [Google Scholar] [CrossRef]
- Rodríguez-Jasso, R.M.; Mussato, S.I.; Pastrana, L.; Aguilar, C.N.; Teixeira, J.A. Chemical composition and antioxidant activity of sulphated polysaccharides extracted from Fucus vesiculosus using different hydrothermal processes. Chem. Pap. 2014, 68, 203–209. [Google Scholar] [CrossRef]
- Rodríguez-Jasso, R.M.; Mussato, S.I.; Pastrana, L.; Aguilar, C.N.; Teixeira, J.A. Extraction of sulfated polysaccharides by autohydrolysis of brown seaweed Fucus vesiculosus. J. Appl. Phycol. 2013, 25, 31–39. [Google Scholar] [CrossRef]
- Thompson, T.M.; Young, B.R.; Baroutian, S. Advances in the pretreatment of brown macroalgae for biogas production. Fuel Process. Technol. 2019, 195, 106151. [Google Scholar] [CrossRef]
- Saxena, R.; Rosero-Chasoy, G.; Aparicio, E.; Lara, A.; Loredo, A.; Robledo, A.; Kostas, E.T.; Rodríguez-Jasso, R.M.; Ruiz, H.A. Third generation biorefineries using micro-macro-alge. In Production of Biofuels and Chemicals from Sustainable Recycling of Organic Solid Waste; Fang, Z., Smith, R.L., Jr., Xu, L., Eds.; Springer: Singapore, 2022; pp. 373–411. [Google Scholar]
- Salgado, C.L.; Muñoz, R.; Blanco, A.; Lienqueo, M.E. Valorization and upgrading of the nutritional value of seaweed and seaweed waste using the marine fungi Paradendryphiella salina to produce mycoprotein. Algal Res. 2020, 53, 102135. [Google Scholar] [CrossRef]
- Liu, S. (Ed.) How cells grow. In Bioprocess Engineering; Elsevier: Amsterdam, The Netherlands, 2013; pp. 549–606. [Google Scholar]
- Pilgaard, B.; Wilkens, C.; Herbst, F.-A.; Vuillemin, M.; Rhein-Knudsen, N.; Meyer, A.S.; Lange, L. Proteomic enzyme analysis of the marine fungus Paradendryphiella salina reveals alginate lyase as a minimal adaptation strategy for brown algae degradation. Sci. Rep. 2019, 9, 12338. [Google Scholar] [CrossRef] [PubMed]
- Sankaranarayanan, S.; Hariram, M.; Vivekanandhan, S.; Navia, R. Sustainable biocarbon materials derived from Lessonia Trabeculata macroalgae biomass residue for supercapacitor applications. Energy Storage 2021, 3, e222. [Google Scholar] [CrossRef]
- Talekar, S.; Patti, A.F.; Singh, R.; Vijayraghavan, R.; Arora, A. From waste to wealth: High recovery of nutraceuticals from pomegranate seed waste using a green extraction process. Ind. Crops Prod. 2018, 112, 790–802. [Google Scholar] [CrossRef]
- Sukri, A.; Othman, R.; Abd-wahab, F.; Noor, N.M. Self-sustaining bioelectrochemical cell from fungal degradation of lignin-rich agrowaste. Energies 2021, 14, 2098. [Google Scholar] [CrossRef]
- Cernadas, H.; Flórez-fernández, N.; González, M.J.; Domínguez, H.; Torres, M.D. Retrieving of high-value biomolecules from edible Himanthalia elongata brown seaweed using hydrothermal processing. Food Bioprod. Process. 2019, 117, 275–286. [Google Scholar] [CrossRef]
- Rani, V.; Shakila, R.J.; Jawahar, P.; Srinivasan, A. Influence of species, geographic location, seasonal variation and extraction method on the fucoidan yield of the brown seaweeds of Gulf of Mannar, India. Indian J. Pharm. Sci. 2017, 79, 65–71. [Google Scholar] [CrossRef]
- Del Río, P.G.; Domínguez, E.; Domínguez, V.D.; Romaní, A.; Domingues, L.; Garrote, G. Third generation bioethanol from invasive macroalgae Sargassum muticum using autohydrolysis pretreatment as first step of a biorefinery. Renew. Energy 2019, 141, 728–735. [Google Scholar] [CrossRef]
- Sukwong, P.; Sunwoo, I.Y.; Lee, M.J.; Ra, C.H.; Jeong, G.-T.; Kim, S.-K. Application of the severity factor and HMF removal of red macroalgae Gracilaria verrucosa to production of bioethanol by Pichia stipitis and Kluyveromyces marxianus with adaptive evolution. Appl. Biochem. Biotechnol. 2019, 187, 1312–1327. [Google Scholar] [CrossRef]
- Rupérez, P. Mineral content of edible marine seaweeds. Food Chem. 2002, 79, 23–26. [Google Scholar] [CrossRef]
- Kumar, S.; Sahoo, D.; Levine, I. Assessment of nutritional value in a brown seaweed Sargassum wightii and their seasonal variations. Algal Res. 2015, 9, 117–125. [Google Scholar] [CrossRef]
- Thadhani, V.M.; Lobeer, A.; Zhang, W.; Irfath, M.; Su, P.; Edirisinghe, N.; Amaratunga, G. Comparative analysis of sugar and mineral content of Sargassum spp. collected from different coasts of Sri Lanka. J. Appl. Phycol. 2019, 31, 2643–2651. [Google Scholar] [CrossRef]
- Sadeghi, S.A.T.; Kamali, A.A.; Kabirifard, A.M. Determination of heavy metals in Sargassum angustifolium marine alga of south west coasts of Iran for using in animal nutrition. Bull. Environ. Pharmacol. Life Sci. 2014, 3, 261–265. [Google Scholar]
- Miao, L.; Yan, W.; Zhong, L.; Xu, W.; Bay, D. Effect of heavy metals (Cu, Pb, and As) on the ultrastructure of Sargassum pallidum in Daya Bay, China. Environ. Monit. Assess. 2014, 186, 87–95. [Google Scholar] [CrossRef]
- Ungureanu, G.; Santos, S.; Boaventura, R.; Botelho, C. Biosorption of antimony by brown algae S. muticum and A. nodosum. Environ. Eng. Manag. J. 2015, 14, 455–463. [Google Scholar]
- Santos, S.C.R.; Ungureanu, G.; Volf, I.; Boaventura, R.A.R.; Botelho, M.S. Macroalgae biomass as sorbent for metal ions. In Biomass and Renewable Raw Material to Obtain Bioproducts of High-Tech Value; Popa, V., Volf, I., Eds.; Elsevier: Amsterdam, The Netherlands, 2018; pp. 69–112. [Google Scholar]
- Al-Homaidan, A.A.; Al-Ghanayem, A.A.; Al-Qahtani, H.S.; Al-Abbad, A.F.; Alabdullatif, J.A.; Alwakeel, S.S.; Ameen, F. Effect of sampling time on the heavy metal concentrations of brown algae: A bioindicator study on the Arabian Gulf coast. Chemosphere 2021, 263, 127998. [Google Scholar] [CrossRef]
- Ruiz, H.A.; Galbe, M.; Garrote, G.; Ramirez-Gutierrez, D.M.; Ximenes, E.; Sun, S.-N.; Lachos-Perez, D.; Rodríguez-Jasso, R.M.; Sun, R.-C.; Yang, B.; et al. Severity factor kinetic model as a strategic parameter of hydrothermal processing (steam explosion and liquid hot water) for biomass fractionation under biorefinery concept. Bioresour. Technol. 2021, 342, 125961. [Google Scholar] [CrossRef]
- Ruiz, H.A.; Thomsen, M.H.; Trajano, H.L. Hydothermal Processing in Biorefineries, 1st ed.; Springer: Cham, Switzerland, 2017; pp. v–viii. [Google Scholar]
- Pino, M.S.; Rodríguez-Jasso, R.M.; Michelin, M.; Ruiz, H.A. Enhancement and modeling of enzymatic hydrolysis on cel-lulose from agave bagasse hydrothermally pretreated in a horizontal bioreactor. Carbohydr. Polym. 2019, 211, 349–359. [Google Scholar] [CrossRef]
- Aguilar, D.L.; Rodríguez-Jasso, R.M.; Zanuso, E.; de Rodríguez, D.J.; Amaya-Delgado, L.; Sanchez, A.; Ruiz, H.A. Scale-up and evaluation of hydrothermal pretreatment in isothermal and non-isothermal regimen for bioethanol pro-duction using agave bagasse. Bioresour. Technol. 2018, 263, 112–119. [Google Scholar] [CrossRef]
- Ask, M.; Bettiga, M.; Mapelli, V.; Olsson, L. The influence of HMF and furfural on redox-balance and energy-state of xylose-utilizing Saccharomyces cerevisiae. Biotechnol. Biofuels 2013, 22, 6. [Google Scholar] [CrossRef]
- Kratky, L.; Jirout, T. Biomass size reduction machines for enhancing biogas production. Chem. Eng. Technol. 2011, 34, 391–399. [Google Scholar] [CrossRef]
- Te Biesebeke, R.; Ruijter, G.; Rahardjo, Y.S.; Hoogschagen, M.J.; Heerikhuisen, M.; Levin, A.; van Driel, K.G.; Schutyser, M.A.; Dijksterhuis, J.; Zhu, Y.; et al. Aspergillus oryzae in solid-state and submerged fermentations. FEMS Yeast Res. 2002, 2, 245–248. [Google Scholar] [CrossRef] [PubMed][Green Version]
- Pinales-Márquez, C.D.; Rodríguez-Jasso, R.M.; Araújo, R.G.; Loredo-Treviño, A.; Nabarlatz, D.; Gullón, B.; Ruiz, H.A. Circular bioeconomy and integrated biorefinery in the production of xylooligosaccharides from lignocellulosic bio-mass. A review. Ind. Crops Prod. 2021, 162, 113274. [Google Scholar] [CrossRef]
- Duchesne, I.; Hult, E.; Molin, U.; Daniel, G.; Iversen, T.; Lennholm, H. The influence of hemicellulose on fibril aggregation of kraft pulp fibres as revealed by FE-SEM and CP/MAS 13C-NMR. Cellulose 2001, 8, 103–111. [Google Scholar] [CrossRef]
- Pérez-Larrán, P.; Torres, M.D.; Flórez-Fernández, N.; Balboa, E.M.; Moure, A.; Domínguez, H. Green technologies for cascade extraction of Sargassum muticum bioactives. J. Appl. Phycol. 2019, 31, 2481–2495. [Google Scholar] [CrossRef]
- Schultz-Jensen, N.; Thygesen, A.; Leipold, F.; Thomsen, S.T.; Roslander, C.; Lilholt, H.; Bjerre, A.B. Pretreatment of the macroalgae Chaetomorpha linum for the production of bioethanol—Comparison of five pretreatment technologies. Bioresour. Technol. 2013, 140, 36–42. [Google Scholar] [CrossRef] [PubMed]
- Meinita, M.D.N.; Hong, Y.-K.; Jeong, G.-T. Comparison of sulfuric and hydrochloric acids as catalysts in hydrolysis of Kappaphycus alvarezii (cottonii). Bioprocess Biosyst. Eng. 2012, 35, 123–128. [Google Scholar] [CrossRef]
- Elsayed, M.; Abomohra, A.E.-F.; Ai, P.; Wang, D.; El-Mashad, H.M.; Zhang, Y. Biorefining of rice straw by sequential fermentation and anaerobic digestion for bioethanol and/or biomethane production: Comparison of structural properties and energy output. Bioresour. Technol. 2018, 268, 183–189. [Google Scholar] [CrossRef]
- Matyja, K.; Wasiela, A.; Dobicki, W.; Pokorny, P.; Trusek, A. Dynamic modeling of the activated sludge microbial growth and activity under exposure to heavy metals. Bioresour. Technol. 2021, 339, 125623. [Google Scholar] [CrossRef]
- Gola, D.; Chawla, P.; Malik, A.; Ahammad, S.Z. Development and performance evaluation of native microbial consortium for multi metal removal in lab scale aerobic and anaerobic bioreactor. Environ. Technol. Innov. 2020, 18, 100714. [Google Scholar] [CrossRef]
- Chen, Y.; Chen, Y.; Li, Y.; Wu, Y.; Zeng, Z.; Xu, R.; Wang, X.; Li, H.; Zhang, J. Changes of heavy metal fractions during co-composting of agricultural waste and river sediment with inoculation of Phanerochaete chrysosporium. J. Hazard. Mater. 2019, 378, 120757. [Google Scholar] [CrossRef] [PubMed]
- Bianco, A.; Budroni, M.; Zara, S.; Mannazzu, I.; Fancello, F.; Zara, G. The role of microorganisms on biotransformation of brewers’ spent grain. Appl. Microbiol. Biotechnol. 2020, 104, 8661–8678. [Google Scholar] [CrossRef] [PubMed]
- Suraiya, S.; Lee, J.M.; Cho, H.J.; Jang, W.J.; Kim, D.G.; Kim, Y.O.; Kong, I.S. Monascus spp. fermented brown seaweeds extracts enhance bio-functional activities. Food Biosci. 2018, 21, 90–99. [Google Scholar] [CrossRef]
- Stoffel, F.; Santana, W.D.O.; Fontana, R.C.; Gregolon, J.G.N.; Kist, T.B.L.; De Siqueira, F.G.; Mendonça, S.; Camassola, M. Chemical features and bioactivity of grain flours colonized by macrofungi as a strategy for nutritional enrichment. Food Chem. 2019, 297, 124988. [Google Scholar] [CrossRef]
- Schaumann, K.; Weide, G. Efficiency of uronic acid uptake in marine alginate-degrading fungi. Helgoländer Meeresunters. 1995, 49, 159–167. [Google Scholar] [CrossRef]
- Chutmanop, J.; Chuichulcherm, S.; Chisti, Y.; Srinophakun, P. Protease production by Aspergillus oryzae in solid-state fermentation using agroindustrial substrates. J. Chem. Technol. Biotechnol. 2008, 83, 1012–1018. [Google Scholar] [CrossRef]
- Londoño-Hernandez, L.; Ruiz, H.A.; Ramirez, C.; Ascacio, J.A.; Rodríguez-Herrera, R.; Aguilar, C.N. Fungal detoxification of coffee pulp by solid-state fermentation. Biocatal. Agric. Biotechnol. 2019, 23, 101467. [Google Scholar] [CrossRef]
- Olukomaiya, O.O.; Fernando, W.C.; Mereddy, R.; Li, X.; Sultanbawa, Y. Solid-state fermentation of canola meal with Aspergillus sojae, Aspergillus ficuum and their co-cultures: Effects on physicochemical, microbiological and functional properties. LWT-Food Sci. Technol. 2020, 127, 109362. [Google Scholar] [CrossRef]
- Zhong, Y.; Lu, X.; Xing, L.; Ho, S.W.A.; Kwan, H.S. Genomic and transcriptomic comparison of Aspergillus oryzae strains: A case study in soy sauce koji fermentation. J. Ind. Microbiol. Biotechnol. 2018, 45, 839–853. [Google Scholar] [CrossRef]
- Lani, N.; Husaini, A.; Ngieng, N.S.; Lee, K.S.; Rahim, K.A.A.; Roslan, H.A.; Esa, Y. Solid substrate fermentation of sago waste and its evaluation as feed ingredient for red hybrid tilapia. Malays Appl. Biol. 2021, 50, 85–94. [Google Scholar] [CrossRef]
- Aruna, T.E. Production of value-added product from pineapple peels using solid state fermentation. Innov. Food Sci. Emerg. Technol. 2019, 57, 102193. [Google Scholar] [CrossRef]
- Ezekiel, O.O.; Aworh, O.C.; Blaschek, H.P.; Ezeji, T.C. Protein enrichment of cassava peel by submerged fermentation with Trichoderma viride (ATCC 36316). Afr. J. Biotechnol. 2010, 9, 187–194. [Google Scholar]
- Brain-Isasi, S.; Carú, C.; Lienqueo, M.E. Valorization of the green seaweed Ulva Rigida for production of fungal biomass protein using a hypercellulolytic terrestrial fungus. Algal Res. 2021, 59, 102457. [Google Scholar] [CrossRef]
- Norakma, M.N.; Zaibunnisa, A.H.; Razarinah, W.A.R.W. The changes of phenolics profiles, amino acids and volatile compounds of fermented seaweed extracts obtained through microbial fermentation. Mater. Today Proc. 2022, 48, 815–821. [Google Scholar] [CrossRef]
- Sasaki, Y.; Yoshikuni, Y. Metabolic engineering for valorization of macroalgae biomass. Metab. Eng. 2022, 71, 42–61. [Google Scholar] [CrossRef] [PubMed]
- Dai, C.; Hou, Y.; Xu, H.; Huang, L.; Dabbour, M.; Mintah, B.K.; He, R.; Ma, H. Effect of solid-state fermentation by three different Bacillus species on composition and protein structure of soybean Meal. J. Sci. Food Agric. 2022, 102, 557–566. [Google Scholar] [CrossRef]
- Zabermawi, N.M.; Alsulaimany, F.A.S.; El-Saadony, M.T.; El-Tarabily, K.A. New eco-friendly trends to produce biofuel and bioenergy from microorganisms: An updated review. Saudi J. Biol. Sci. 2022. [Google Scholar] [CrossRef]
- Ghosh, S.; Sarkar, T.; Pati, S.; Kari, Z.A.; Edinur, H.A.; Chakraborty, R. Novel bioactive compounds from marine sources as a tool for functional food development. Front. Mar. Sci. 2022, 9, 832957. [Google Scholar] [CrossRef]
- Soares, G.A.; Alnoch, R.C.; Dias, G.S.; Reis, N.dS.; Tavares, I.M.C.; Ruiz, H.A.; Bilal, M.; de Oliveira, J.R.; Krieger, N.; Franco, M.F. Production of a fermented solid containing lipases from Penicillium roqueforti ATCC 10110 and its direct employment in organic medium in ethyl oleate synthesis. Appl. Biochem. Biotechnol. 2021. [Google Scholar] [CrossRef]
- Liao, A.M.; Zhang, J.; Yang, Z.L.; Huang, J.H.; Pan, L.; Hou, Y.C.; Li, X.X.; Zhao, P.H.; Dong, Y.Q.; Hu, Z.Y.; et al. Structural, physicochemical, and functional properties of wheat bran insoluble dietary fiber modified with probiotic fermentation. Front. Nutr. 2022, 9, 803440. [Google Scholar] [CrossRef]
- Kong, Q.; Zhang, R.; You, L.; Ma, Y.; Liao, L.; Pedisic, S. In vitro fermentation characteristics of polysaccharide from Sargassum Fusiforme and its modulation effects on gut microbiota. Food Chem. Toxicol. 2021, 151, 112145. [Google Scholar] [CrossRef] [PubMed]
- Hasanin, M.S.; Mostafa, A.M.; Mwafy, E.A.; Darwesh, O.M. Eco-friendly cellulose nano fibers via first reported Egyptian Humicola Fuscoatra Egyptia X4: Isolation and characterization. Environ. Nanotechnol. Monit. Manag. 2018, 10, 409–418. [Google Scholar] [CrossRef]
- Xue, P.; Liao, W.; Chen, Y.; Xie, J.; Chang, X.; Peng, G.; Huang, Q.; Wang, Y.; Sun, N.; Yu, Q. Release characteristic and mechanism of bound Polyphenols from insoluble dietary fiber of navel orange peel via mixed solid-state fermentation with Trichoderma reesei and Aspergillus niger. LWT-Food Sci. Technol. 2022, 161, 113387. [Google Scholar]
- Almeida, F.P.; Freire DM, G.; Lins, U.; Gutarra, M.L.E. Surface imaging of the filamentous fungus Penicillium Simplicissimum growing in a solid-state fermentation system. Micron 2017, 99, 19–25. [Google Scholar] [CrossRef]
- AOAC (1990a) Method 988.05. In Official Methods of Analysis, 15th ed.; Helrich, K., Ed.; The Association of Official Analytical Chemists, Inc.: Arlington, TX, USA, 1990. [Google Scholar]
- Sluiter, A.; Hames, R.; Ruiz, R.; Scarlata, C.; Sluiter, J.; Templeton, D. Determination of Ash in Biomass; NREL/TP-510-42622. NREL Analytical Procedure; National Renewable Energy Laboratory: Golden, CO, USA, 2008.
- Yemm, E.W.; Willis, A. The estimation of carbohydrates in plant extracts by Anthrone. Biochem. J. 1954, 57, 508–514. [Google Scholar] [CrossRef] [PubMed]
- Sluiter, A.; Hames, B.; Ruiz, R.; Scarlata, C.; Sluiter, J.; Templeton, D.; Crocker, D.L.A.P. Determination of Structural Carbohydrates and Lignin in Biomass; NREL Analytical Procedure; National Renewable Energy Laboratory: Golden, CO, USA, 2008.

| Chemical Composition | Seaweed g/100 g (d.w.) | Minerals | Concentration (mg/kg) | Heavy Metals | Concentration (mg/kg) | Codex Alimentarius (mg/kg) | Official Mexican Standard for Food (mg/kg) |
|---|---|---|---|---|---|---|---|
| Protein (%) | 4.3 ± 0.07 | Magnesium (Mg) | 13.45 ± 0.00 | Arsenic (As) | 8.81 × 10−2 ± 0.00 | 0.2 | 0.2 |
| Glucan | 11.64 ± 0.01 | Phosphorus (P) | 2.44 ± 0.00 | Cadmium (Cd) | 1.82 × 10−3 ± 0.00 | 0.4 | |
| Galactan | 0.99 ± 0.01 | Sulfur (S) | 15.51 ± 0.00 | Lead (Pb) | 2.32 × 10−5 ± 0.00 | 0.2 | 0.1 |
| Fucoidan | 3.18 ± 0.01 | Potassium (K) | 3.12 ± 0.00 | Mercury (Hg) | 4.10 × 10−3 ± 0.00 | 0.1 | 0.05 |
| Insoluble acid residue | 29 ± 0.01 | Calcium (Ca) | 136.16 ± 0.00 | Tin (Sn) | 3.25 × 10−2 ± 0.00 | 250; 150; 50 | 250 |
| Ash | 15.46 ± 0.40 | Manganese (Mn) | 0.11 ± 0.00 | ||||
| Iron (Fe) | 0.31 ± 0.00 | ||||||
| Zinc (Zn) | 0.11 ± 0.00 | ||||||
| Iodine (I) | 0.17 ± 0.00 |
| Operating Conditions | 150 °C | 170 °C | 190 °C |
|---|---|---|---|
| Time (min) | 50 | 50 | 50 |
| Pressure (bar) | 3.75 | 6.91 | 11.54 |
| Severity process [logRo] | 4.03 | 4.13 | 4.20 |
| Temperature (°C) | |||
|---|---|---|---|
| Chemical components | 150 | 170 | 190 |
| Glucan | 17.99 ± 0.1 | 23.86 ± 0.1 | 25.38 ± 0.1 |
| Minerals | Time (h) | ||
| (mg/kg) | 24 | 72 | 120 |
| Phosphorus (P) | 1.71 × 10−4 ± 0.00 | 1.34 × 10−4 ± 0.00 | 1.51 × 10−4 ± 0.10 |
| Sulfur (S) | 4.33 × 10−4 ± 0.00 | 3.73 × 10−4 ± 0.00 | 3.86 × 10−4 ± 0.00 |
| Potassium (K) | 1.36 × 10−5 ± 0.00 | 1.18 × 10−5 ± 0.00 | 2.59 × 10−5 ± 0.00 |
| Calcium (Ca) | 1.33 × 10−2 ± 0.00 | 1.30 × 10−2 ± 0.00 | 1.22 × 10−2 ± 0.00 |
| Manganese (Mn) | 1.58 × 10−5 ± 0.00 | 1.76 × 10−5 ± 0.00 | 1.47 × 10−5 ± 0.00 |
| Iron (Fe) | 7.32 × 10−5 ± 0.00 | 5.36 × 10−5 ± 0.00 | 1.05 × 10−4 ± 0.00 |
| Zinc (Zn) | 9.81 × 10−6 ± 0.00 | 1.25 × 10−5 ± 0.00 | 1.12 × 10−5 ± 0.00 |
| Iodine (I) | 3.77 × 10−6 ± 0.00 | 2.20 × 10−6 ± 0.00 | 4.91 × 10−6 ± 0.00 |
| Heavy Metals | Time (h) | ||
| (mg/kg) | 24 | 72 | 120 |
| Arsenic (As) | 3.24 × 10−6 ± 0.00 | 3.23 × 10−6 ± 0.00 | 1.15 × 10−6 ± 0.00 |
| Cadmium (Cd) | 2.42 × 10−3 ± 0.00 | 4.40 × 10−5 ± 0.00 | 2.10 × 10−3 ± 0.00 |
| Lead (Pb) | 5.09 × 10−3 ± 0.00 | 4.50 × 10−3 ± 0.00 | 3.10 × 10−3 ± 0.00 |
| Mercury (Hg) | 1.40 × 10−3 ± 0.00 | 2.90 × 10−3 ± 0.00 | 2.68 × 10−3 ± 0.00 |
| Tin (Sn) | 1.81 × 10−6 ± 0.00 | 1.91 × 10−6 ± 0.00 | 1.61 × 10−6 ± 0.00 |
Publisher’s Note: MDPI stays neutral with regard to jurisdictional claims in published maps and institutional affiliations. |
© 2022 by the authors. Licensee MDPI, Basel, Switzerland. This article is an open access article distributed under the terms and conditions of the Creative Commons Attribution (CC BY) license (https://creativecommons.org/licenses/by/4.0/).
Share and Cite
Bonilla Loaiza, A.M.; Rodríguez-Jasso, R.M.; Belmares, R.; López-Badillo, C.M.; Araújo, R.G.; Aguilar, C.N.; Chávez, M.L.; Aguilar, M.A.; Ruiz, H.A. Fungal Proteins from Sargassum spp. Using Solid-State Fermentation as a Green Bioprocess Strategy. Molecules 2022, 27, 3887. https://doi.org/10.3390/molecules27123887
Bonilla Loaiza AM, Rodríguez-Jasso RM, Belmares R, López-Badillo CM, Araújo RG, Aguilar CN, Chávez ML, Aguilar MA, Ruiz HA. Fungal Proteins from Sargassum spp. Using Solid-State Fermentation as a Green Bioprocess Strategy. Molecules. 2022; 27(12):3887. https://doi.org/10.3390/molecules27123887
Chicago/Turabian StyleBonilla Loaiza, Adriana M., Rosa M. Rodríguez-Jasso, Ruth Belmares, Claudia M. López-Badillo, Rafael G. Araújo, Cristóbal N. Aguilar, Mónica L. Chávez, Miguel A. Aguilar, and Héctor A. Ruiz. 2022. "Fungal Proteins from Sargassum spp. Using Solid-State Fermentation as a Green Bioprocess Strategy" Molecules 27, no. 12: 3887. https://doi.org/10.3390/molecules27123887
APA StyleBonilla Loaiza, A. M., Rodríguez-Jasso, R. M., Belmares, R., López-Badillo, C. M., Araújo, R. G., Aguilar, C. N., Chávez, M. L., Aguilar, M. A., & Ruiz, H. A. (2022). Fungal Proteins from Sargassum spp. Using Solid-State Fermentation as a Green Bioprocess Strategy. Molecules, 27(12), 3887. https://doi.org/10.3390/molecules27123887

